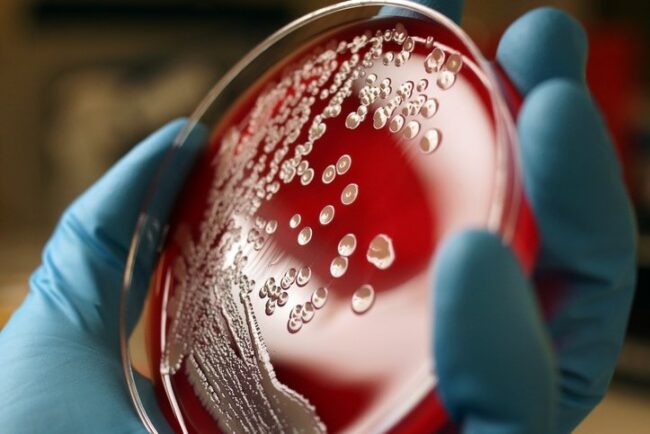
oscabecasdanoticia-colon.jpg

Portugal tem 45 mil vagas abertas e está em busca de brasileiros
O turismo em Portugal tem se fortalecido a cada ano e, nos primeiros cinco meses de 2023, o número de pessoas que visitou o país cresceu, sendo até agora o ano que registrou o maior nível de procura na história de Portugal. Com o mercado turístico aquecido, as vagas de emprego aumentam, e de acordo…